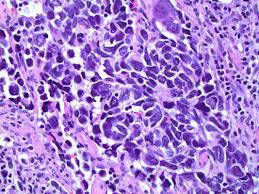

Press release
Neuroendocrine Carcinoma Market Report 2018: Segmentation by Product (Chemotherapy, Somatostatin Analogs, Targeted Therapy, Others) by Application (Hospital, Clinics, Oncology Centres, Ambulatory Surgery Centres, Others)
Global Neuroendocrine Carcinoma market research report provides company profile for Teva, F.Hoffmann-La Roche, Advanced Accelerator, Mateon, Lexicon, Pfizer, Novartis, Chiasma, Ipsen, Abbvie, Valeant, Jubilant and Others.This market study includes data about consumer perspective, comprehensive analysis, statistics, market share, company performances (Stocks), historical analysis 2012 to 2017, market forecast 2018 to 2025 in terms of volume, revenue, YOY growth rate, and CAGR for the year 2018 to 2025, etc. The report also provides detailed segmentation on the basis of product type, application, end user and regional segmentation. The regional segment is further bifurcated on country level.
Neuroendocrine tumors (NETs) are neoplasms that arise from cells of the endocrine (hormonal) and nervous systems. Many are benign, while some are malignant. They most commonly occur in the intestine, where they are often called carcinoid tumors, but they are also found in the pancreas, lung and the rest of the body.
Request for Free sample copy of ready Report @ http://marketreportscompany.com/contact.php
Report Coverage:
Top Manufactures/vendors of Neuroendocrine Carcinoma market:
Pfizer
Novartis
Chiasma
Ipsen
Abbvie
Valeant
Jubilant
Teva
F.Hoffmann-La Roche
Advanced Accelerator
Mateon
Lexicon
Others (Note: We can profile additional players without any additional charges)
Neuroendocrine Carcinoma Product Type:
Chemotherapy
Somatostatin Analogs
Targeted Therapy
Others
Application of Neuroendocrine Carcinoma:
Hospital
Clinics
Oncology Centres
Ambulatory Surgery Centres
Others
Regions covered in Neuroendocrine Carcinoma Market Research Report:
North America (USA, Canada and Mexico)
Europe (Germany, France, UK, Russia, Italy and Others)
Asia-Pacific (China, Japan, Korea, India, Southeast Asia and Others)
South America (Brazil, Argentina, Columbia and Others)
Middle East and Africa (Saudi Arabia, UAE, Egypt, Nigeria, South Africa and Others)
(Note: We can provide country or region specific report on request; please contact us for your specific requirement)
The Global Neuroendocrine Carcinoma Market analysis report covers detailed value chain analysis of Global Neuroendocrine Carcinoma Market. The value chain analysis helps to analyze major upstream raw materials, major equipment’s, manufacturing process, downstream customer analysis and major distributor analysis.
The report also covers in-depth description, competitive scenario, wide product portfolio of prime players active in this market and business strategies adopted by competitors along with their SWOT analysis. The report also provides Porter analysis, PESTEL analysis and market attractiveness which helps to better understand the market scenario on macro and micro level. Side by side, it also explicitly provides information about mergers, acquisitions, joint ventures, and all the other important activities occurred in the market during current and past few years. The Global Neuroendocrine Carcinoma Market report explores manufacturer’s competitive scenario and provides market share for all major players of this market based on production capacity, sales, revenue, geographical presence and other major factors. The report also covers import/export data across all major regions covered in this report. Moreover, we can exclusively provide information about import/export data across any particular country as per requirement.
How helpful this report will be?
• Neuroendocrine Carcinoma Market share (regional, product, application, end-user) both in terms of volume and revenue along with CAGR from 2018 to 2025
• Key parameters which are driving this market and restraining its growth
• What all challenges manufacturers will face as well as new opportunities and threats faced by them
Enquire before Buying @ http://marketreportscompany.com/contact.php......
Table of Content:
1 Neuroendocrine Carcinoma Market Overview
1.1 Product Overview and Scope of Neuroendocrine Carcinoma
1.2 Classification of Neuroendocrine Carcinoma by Product Category
1.2.1 Global Neuroendocrine Carcinoma Market Size (Sales) Comparison by Type (2013-2025)
1.2.2 Global Neuroendocrine Carcinoma Market Size (Sales) Market Share by Type (Product Category) in 2017
1.2.3 Chemotherapy
1.2.4 Somatostatin Analogs
1.2.5 Targeted Therapy........................Continue (http://marketreportscompany.com/contact.php)
What does Report Include?
Historic Data: What was the Neuroendocrine Carcinoma Market data (Size, competition, company share, YoY growth rate, etc.) from 2013 to 2018.
Current Market Status: A comprehensive analysis of current market Size, trends, growth drivers, industry pitfalls, challenges and opportunities for players.
Market Forecast: Report will comment and provide details about market growth and forecast till year 2025.
Customization: We can provide following things 1) On request more company profiles (competitors) 2) Data about particular country or region 3) We will incorporate the same with no additional cost (Post conducting feasibility).
Contact Us
Jason Smith,
Sales Manager, Global Business Development,
Website: marketreportscompany.com
Email: jasonsmith@marketreportscompany.com
Contact us: +1-312-376-8303
Address: 20 N State Street, Chicago, Illinois, 60602 United States
This release was published on openPR.
Permanent link to this press release:
Copy
Please set a link in the press area of your homepage to this press release on openPR. openPR disclaims liability for any content contained in this release.
You can edit or delete your press release Neuroendocrine Carcinoma Market Report 2018: Segmentation by Product (Chemotherapy, Somatostatin Analogs, Targeted Therapy, Others) by Application (Hospital, Clinics, Oncology Centres, Ambulatory Surgery Centres, Others) here
News-ID: 1386089 • Views: …
More Releases for Product
Genstore Ranks #1 Product of the Day on Product Hunt
Los Angeles - September 11, 2025 - Genstore [https://www.genstore.ai/], an AI-native e-commerce platform, ranked #1 Product of the Day on Product Hunt and emerged as one of the week's top-trending products. The recognition underscores strong community support for Genstore's mission to make advanced commerce simple, accessible, and cost-efficient for small and medium-sized businesses worldwide.
Image: https://www.globalnewslines.com/uploads/2025/09/ab03aa9cb9a17e4c42e998d53f216bde.jpg
"Genstore lets anyone start selling online with just a prompt. But of course, that's just the…
Large Volume Parenteral Product Market New Product Development & Latest Trends
The global Large Volume Parenteral (LVP) market is poised for significant growth, projected to reach a value of approximately $12.5 billion in 2024. During the forecast period from 2025 to 2034, the market is expected to expand at a robust Compound Annual Growth Rate (CAGR) of 6.5%, culminating in an estimated market value of $22 billion by 2034.
Exactitude Consultancy., Ltd. released a research report offers a comprehensive examination of the…
Product technology, product usage tips, industry trends
Product Craftsmanship: Yiwu LABON Stationery Co., Ltd. Showcases Superior Craftsmanship in OEM Notebooks
Yiwu LABON Stationery Co., Ltd., established in 2003, has built a reputation for exceptional craftsmanship in the OEM notebook industry. Our factory-based company combines traditional techniques with modern innovation to create notebooks that stand out for their quality and design. Each notebook crafted by Yiwu LABON represents a meticulous process where attention to detail and precision are paramount.…
Product List: The Ultimate Destination for Product and Deal Discovery
Finding the right product or tool to suit your needs can be a daunting task, and securing the best deal on them can be equally challenging.
Each day, plenty of tools are launched, each with unique use cases. Individuals across various industries can benefit from these tools as they simplify their tasks compared to traditional methods. However, it's essential to consider the cost, as some tools are free while others come…
Logistics Packaging Market Enhance Product Safety, Maintain Product Quality, Ext …
MarketResearchReports.Biz presents this most up-to-date research on "Logistics Packaging Market: Global Industry Analysis 2013-2017 and Opportunity Assessment 2018-2028"
The global logistics sector continues to develop at an impressive rate. As a result, the packaging industry is undergoing enormous changes with specified focus on posing innovative packaging tools/products to various industry verticals. Logistics packaging is primarily done to enhance product safety, maintain product quality, extended product storage, and cater to other aspects…
Product News: Release of Product Update
Here’s some important product news for EXA40/EXA24160 and EXA48600/EXA32100. The last software versions include several new features that improve our solutions further. Our latest product update is part of our ongoing effort to offer better and improved products to meet the needs of the changing network infrastructure.
EXA40/EXA24160 Version 1.6.2
Generic Header Stripping
By now the EXA40/EXA24160 supports a generic header stripping function. This function allows removing encapsulations by defining an offset (in…